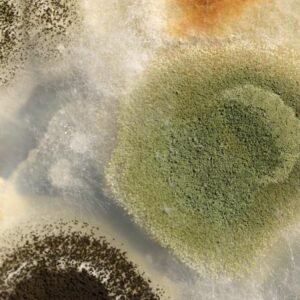
Como Pega Balanite: Sintomas, Tratamentos e Prevenção

8 Maneiras para Eliminar a Balanite e a Balanopostite no Homem

8 Maneiras para Eliminar a Balanite e a Balanopostite. A balanite e a balanopostite são condições desconfortáveis e preocupantes que podem afetar a saúde dos homens.
Ambas envolvem inflamação na região da glande e prepúcio do pênis, causando desconforto e, se não tratadas adequadamente, podem levar a complicações graves.
Neste artigo, exploraremos 8 maneiras eficazes de eliminar a balanite e a balanopostite, restaurando o bem-estar e a confiança masculina.
Compreendendo a Balanite e a Balanopostite
Antes de mergulharmos nas estratégias de tratamento, é importante entender o que são a balanite e a balanopostite. Ambas são condições inflamatórias que afetam a área genital masculina.
A balanite ocorre quando a glande fica inflamada, enquanto a balanopostite envolve a inflamação da glande e do prepúcio. Ambas podem ser causadas por uma variedade de fatores, incluindo infecções bacterianas, fúngicas ou virais, bem como má higiene.
1: Consulte um Profissional de Saúde
O primeiro passo crucial para eliminar a balanite e a balanopostite é consultar um profissional de saúde. Um médico poderá diagnosticar a condição e determinar a causa subjacente. Isso é fundamental para um tratamento eficaz e seguro.
2: Mantenha uma Higiene Adequada
A higiene adequada é fundamental na prevenção e tratamento dessas condições. Lave a área genital diariamente com água morna e sabão suave. Certifique-se de secar completamente a região após o banho.
3: Evite Sabonetes Perfumados e Produtos Químicos Agressivos
Produtos químicos agressivos e sabonetes perfumados podem agravar a irritação. Opte por produtos suaves e hipoalergênicos para a higiene íntima.
Use Roupas Íntimas de Algodão
Roupas íntimas de algodão permitem uma melhor ventilação e reduzem o atrito, ajudando na recuperação.
4: Tratamento Tópico
O médico pode recomendar pomadas ou cremes tópicos para tratar a inflamação e infecção. Siga rigorosamente as orientações do profissional de saúde.
5: Antibióticos ou Antifúngicos
Se a causa for uma infecção bacteriana ou fúngica, o médico pode prescrever antibióticos ou antifúngicos para o tratamento.
6: Evite Relações Sexuais
Até a Recuperação É importante evitar relações sexuais até que a condição esteja completamente resolvida para evitar complicações.
7: Guia Definitivo GD7
Com mais de 18 receitas naturais, você pode eliminar a balanite e a balanopostite em casa, em apenas 7 dias. Recupere seu conforto e bem-estar de forma rápida e segura. Sua jornada para uma saúde íntima renovada.
8: Prevenção Contínua
Após a recuperação, adote práticas de higiene e cuidado contínuos para prevenir futuros episódios de balanite e balanopostite.
CONCLUSÃO: 8 maneiras para eliminar a balanite e a balanopostite
A balanite e a balanopostite podem ser desconfortáveis, mas com o tratamento adequado e cuidados de prevenção, é possível eliminá-las e restaurar a saúde masculina.
Com estas 8 maneiras, os homens podem recuperar o conforto e a confiança na saúde de sua região íntima.

VOCÊ NÃO SABE SE É FIMOSE OU FREIO CURTO, SOFRE COM ISSO E QUER ACABAR COM ESTE PROBLEMA?
Pegue abaixo o seu livro digital, faça o seu diagnóstico e inicie o seu tratamento hoje ainda

[…] de causas e sintomas que demandam atenção médica para um tratamento eficaz. No artigo de hoje veja as principais perguntas sobre […]